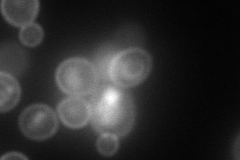
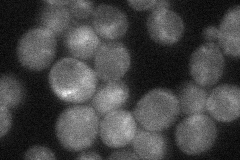
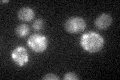

View description
Sphingoid long-chain base kinase, responsible for synthesis of long-chain base phosphates, which function as signaling molecules, regulates synthesis of ceramide from exogenous long-chain bases, localizes to the Golgi and late endosomes
Localization:
Intensity:
Fold change:
Significance:
-
C’ GFP library in SD

cytosol31.38 -
N' NOP1pr-GFP in SD

cell periphery100.479 -
N' TEF2pr-mCherry in SD
cell periphery,vacuole114.672 -
N' NATIVEpr-GFP in SD
ambiguous,punctate35.8611 -
N' TEF2pr-VC and Cyto-VN in SD

cell periphery32.0382 -
C’ GFP library in SD+DTT

cytosolN/AN/ANo -
C’ GFP library in SD+H2O2

cytosolN/AN/ANo -
C’ GFP library in Starvation Media
cytosolN/AN/AYes -
C’ GFP library on the background of Pup2-DaMP

cytosol -
C’ GFP library on the background of CCT mutant

cytosolN/AN/ANo
